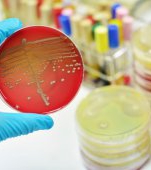

Probleme de sanatate
Afla de aici ce probleme de sanatate poate intampina familia ta! Te invatam cum sa tratezi durerile de cap, hipertensiunile si toate micile afectiuni sau boli care pot sa apara in viata de zi cu zi.

Flatulența reprezintă o problemă se pare nu doar neplăcută, ci poate ascunde în extrem de multe situații o problemă gravă de sănătate. Veți afla aici 10 dintre motivele...

Rana pe col reprezintă o afecțiune extrem de des întâlnită și cu atât mai periculoasă cu cât nu prezintă niciun fel de manifestare clinică. Ce simptome...

Cu siguranță că ți s-a întâmplat, măcar o dată, să observi că nu ai deloc sau aproape deloc poftă de mâncare. Desigur, poate fi vorba despre niște stări...

Stafilococul auriu reprezintă o bacterie comună pentru ființele umane care trăiește pe piele sau în nas. În majoritatea situațiilor acesta este inofensiv, însă dacă...

Streptococul beta-hemolitic implică două categorii principale de streptococi, respectiv cei de grup A și cei de grup B. Există numeroase tipuri de bacterii streptococice, infecțiile pe...
Stafilococul auriu este o bacterie frecvent întâlnită la nivelul pielii sau în interiorul nasului. Deși în majoritatea situațiilor nu este dăunătoare, dacă...

Cu siguranță că unele dintre noi își amintesc adesea cum, cel puțin la începutul copilăriei noastre, a avea parte de banane constituia un lux. Acum însă bananele pot...

Deși cele mai multe specii de păianjen nu prezintă pericol pentru sănătatea umană, există și situații în care se impune o intervenție rapidă pentru a preveni eventualele...

Mușcătura de purice apare de obicei la persoanele care au un animal în gospodărie, însă există și cazuri în care puteți fi ciupiți în afara casei. Iată cum...

Înțepătura de albină reprezintă o problemă cu care se pot confrunta multe persoane în sezonul cald care, în unele situații, poate conduce la șoc anafilactic. Ce...

Înțepătura de viespe constituie o neplăcere des întâlnită în sezonul cald, dar pentru persoanele alergice poate dispune de reacții extinse. Ce trebuie să...
Totul despre problemele de sanatate din familie
Iti prezentam tot ce trebuie sa stii despre eventualele probleme de sanatate din familia ta! Afla de ce boli generale puteti suferi tu si cei apropiati si cum sa le tratezi. De la simplele dureri de cap pana la micile afectiuni si infectii, iti oferim sfaturi pentru toate, pentru ca tu sa te bucuri de o viata normala si sa fii o mamica fericita cu un copil sanatos!